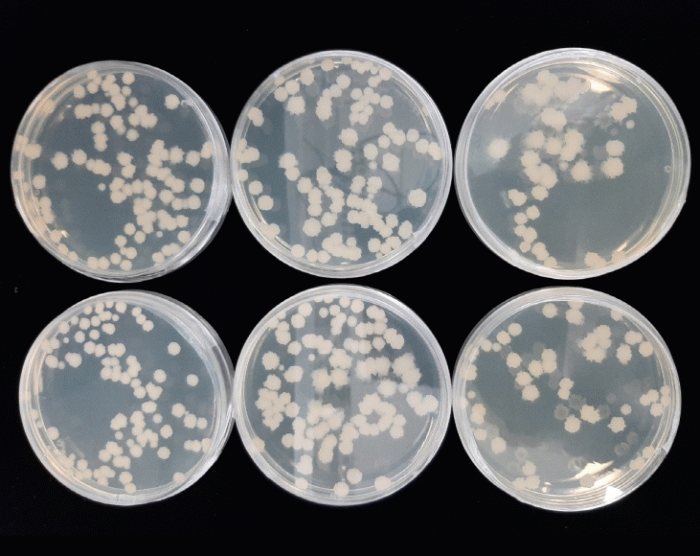

|
À̹ø¿¡ °³¹ßÇÑ ÅäÁ¾ °íÃʱÕ(BC160CK48)Àº ¸ð¼¼Ç÷°üÀ» ¸·¾Æ ³úÁ¹Áß µî ½É°¢ÇÑ Ç÷°üÁúȯÀ» À¯¹ßÇÏ´Â Ç÷¾× ¼Ó Ç÷ÀüÀ» ³ìÀÌ´Â Ç÷Àü¿ëÇØ Ȱ¼º·üÀÌ 87.9%¸¦ ±â·ÏÇß´Ù.
ÀÌ¿Í ÇÔ²² û±¹Àå Á¦Á¶ ½Ã Á¡Áú¹° »ý¼º·ÂÀÌ ¶Ù¾î³ª°í, ¾Æ¹Ì³ëÅ Áú¼Ò¡¤Æú¸®Æä³î µî ±â´É¼º ¼ººÐµµ dzºÎÇØ û±¹ÀåÀ» ºñ·ÔÇÑ °í±â´É¼º Àå·ù Á¦Á¶ ½Ã Ȱ¿ë °¡Ä¡°¡ ³ôÀº °ÍÀÌ Æ¯Â¡ÀÌ´Ù.
±â¼ú¿øÀº ¡®Ç÷Àü¿ëÇØ Ȱ¼º ¿ì¼ö °íÃÊ±Õ ¹× û±¹Àå Á¦Á¶±â¼ú¡¯À» ´çÁø½Ã ¼ÒÀç ¿ÂÇï¾²¹ÙÀÌ¿À(ÁÖ)¿¡ ÀÌÀüÇϸç, ±â¾÷Àº °Ç°½ÄǰÀ¸·Î »ó¿ëÈ ÇÒ ¿¹Á¤ÀÌ´Ù.
µµ ³ó¾÷±â¼ú¿øÀº 2019³âºÎÅÍ ÅäÁ¾ ½Äǰ±ÕÁÖÀÇ ±â´É¼ºÀ» ±Ô¸íÇÏ°í ¼±¹ßÇÏ´Â ¿¬±¸¸¦ Áö¼ÓÇØ ¿Ô´Ù.
±×µ¿¾È °íÃÊ±Õ ¿Ü¿¡µµ ¡â¹Ì¹é È¿°ú¸¦ ³ªÅ¸³»´Â ÅäÁ¾ È¿¸ð(ƯÇãÃâ¿ø 10-2023-0024516È£) ¡âÇ×°üÀý¿° Ȱ¼º ¿ì¼ö È¿¸ð ¹× ¹ßÈ¿ ¼ÒÀç µîÀ» °³¹ßÇÑ ¹Ù ÀÖ´Ù.
ÇöÀç´Â Ä¡¸Å ¿¹¹æ È¿°ú°¡ ³ôÀº ÅäÁ¾ ½Äǰ±ÕÁÖ¸¦ ¼±¹ßÇØ ½Äǰ ¼ÒÀçÈ ¿¬±¸¸¦ ÃßÁø ÁßÀÌ´Ù.
ÀÌÁ¾±¹ ³ó¾÷ȯ°æ¿¬±¸°ú ³ó½ÄǰÀÚ¿øÆÀÀåÀº ¡°ÅäÁ¾ ½Äǰ±ÕÁÖ °³¹ßÀÇ Á߿伺Àº ³¯·Î Ä¿Áö°í ÀÖ°í, ¹ßÈ¿ ½Äǰ ¼ÒÀç´Â ºÎ°¡°¡Ä¡¿Í °æÀï·ÂÀÌ ³ôÀº ºÐ¾ß¡±¶ó¸ç ¡°¾ÕÀ¸·Îµµ µµ³» ³ó½Äǰ »ê¾÷ ¹ßÀüÀ» À§ÇØ ÅäÁ¾ ½Äǰ±ÕÁÖ¿Í ¹ßÈ¿±â¼ú ¿¬±¸¿¡ ÃÖ¼±À» ´ÙÇϰڴ١±°í ¸»Çß´Ù.
Á¶Ç×±¹ ±âÀÚ
2026.03.29(ÀÏ) 22:02